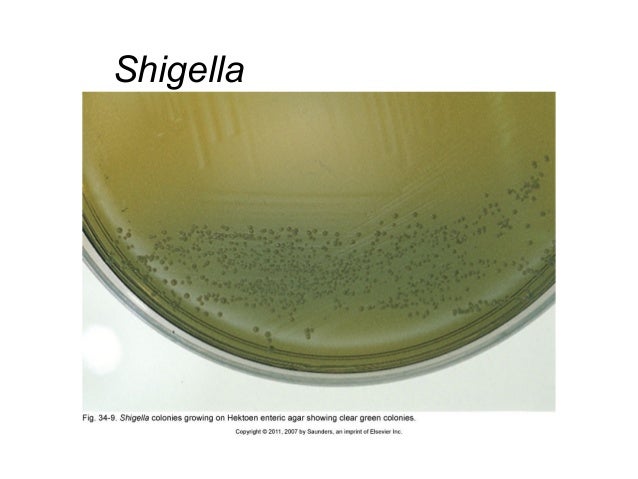

RBC Digital Banking Security Guarantee. Should anything ever happen, we’ve got you covered. We’ll fully reimburse you for any unauthorized transactions 1 made through the RBC Mobile app or RBC Online. Find Out More about the RBC Digital Banking Security Guarantee. The updated RBC Direct Investing Mobile experience on the RBC Mobile 1 app makes it a breeze to evaluate, monitor and take action on your trading strategy. Evaluate Effortlessly Stay in touch with the markets, look up a stock quote, get the latest information or monitor and add to your watchlist.
Rbc mobile app rbc service
I know there’s a handful of you that are going to be pretty happy to hear that there’s finally an official Royal Bank of Canada app for Windows Phone. Head to the Windows Phone Store and you’ll see RBCMobile, a brand new app for all your mobile banking needs. The Royal Bank of Canada ( is the largest financial institution in Canada, so its arrival on Windows Phone is very welcomed. We’re slowly gaining more and more bank apps in the Windows Phone. It’s a big win for the platform every time a new app like this comes to the Windows Phone Store. That said, RBCMobile does exactly what you’d expect from a mobile banking app. Here are the features: Just reading that feature list and it sounds like this app does everything you’d want. Seeing as how RBC serves 18 million clients, we suspect a few of you will be stoked to have this on your phone. Head to the Windows Phone Store to grab the free app. You’ll find things like the ability to check account balance and details, in addition to transfer funds and paying bills. And don’t forget there’s also an RBCMobileapp for Windows 8 that’s been out for quite some time. Microsoft Teams has seen quite the surge in users over the past several months. It seems like a really solid offering for RBC customers. In its Q3 earnings webcast, Microsoft said that it now has 75 million daily active users, up from 44 million users reported in March. No impact Microsoft has shared its Surface and More Personal Computing segment for the third quarter of its 2020 fiscal year. Surface revenue is up 1 percent year over year at $1.3 billion, though the numbers are in line with previous guidance from Microsoft back in January. By the numbers Microsoft reported its Q3 earnings for its 2020 fiscal year today. Overall, the company brought in $35 billion in revenue. That's up 15 percent over Q3 2019, with particular strengths in the cloud and Microsoft 365. Sharing is caring Recording your screen is a great way to create content to share with students, friends, and followers of your stream. From lightweight tools to professional-grade broadcast setups, here are the best screen recorders for Windows 10. You can now play RBCMobile for PC on a desktop/laptop running Windows XP, Windows 7, Windows 8, Windows 8.1, Windows 10 and Mac OS/OS X. This can easily be done with the help of Blue Stacks or Andy OS Android emulator. You told us it was time to refresh our app, and we heard you. We’re excited to bring you a new design that uses the Android‡ technology and gestures you’re used to, so it’s faster and fits more easily into your life. We’ve built the new RBC® Mobile** app** on the Android native operating system to make it quicker and more intuitive. Keep sharing your ratings and comments, because you‘re the best judge of how you want to do your banking. And now, the RBC® Wallet* is a separate app – so you don’t have to sign in to pay. It looks and feels familiar, so you’ll spend less time learning how to use it and more time focusing on everything it helps you to do. Send money to a friend while they’re grabbing you a coffee. —– SECURITY Rest easy knowing that you’re protected from unauthorized transactions*** in the RBCMobileapp by the RBC Online Security Guarantee. Check account balances – without signing in – while in the grocery store lineup. PRIVACY The RBCMobileapp might need to access device services for certain features, like finding nearby RBC Royal Bank® branches. For help removing the RBCMobileapp from your device, there are instructions at you can contact mobile.feedback@ You can get more information about RBC digital channel privacy at Contact information for RBC Royal Bank, RBC Direct Investing and RBC Dominion Securities is available at https:// LEGAL When you select to install the RBCMobileapp, you’re consenting to any future updates or upgrades. Depending on your device, operating system or user-initiated settings, these might be automatically installed. You’re able to withdraw your consent by uninstalling the RBCMobileapp from your device. If you download the RBCMobileapp, you must review, and are subject to, the terms & conditions found under the Legal link on com as well as the following, as applicable: – Electronic Access Agreement (Personal clients of Royal Bank of Canada) – Business Account Agreement (Business clients of Royal Bank of Canada) – The Operation of Account Agreement (RBC Direct Investing clients) – General Account Agreement (RBC Dominion Securities clients) * The RBC Wallet app is operated by Royal Bank of Canada. ** The RBCMobileapp is operated by Royal Bank of Canada, RBC Direct Investing Inc. *** For a definition of an unauthorized transaction & for full details regarding the protections and limitations of the Online Security Guarantees, please see your account &/or online agreements with the applicable entity. The guarantees are given by Royal Bank of Canada, RBC Direct Investing Inc. in connection with their respective online services. RBC and Royal Bank are registered trademarks of Royal Bank of Canada. RBCMobile For PC can be easily installed and used on a desktop computer or laptop running Windows XP, Windows 7, Windows 8, Windows 8.1, Windows 10 and a Macbook, i Mac running Mac OS X. To install RBCMobile For PC, we will use Blue Stacks app player. The method listed below is set to help you get Also Read: Piano Master 2 For PC / Windows 7/8/10 / Mac – Free Download That would be all from our side. In case you have got any queries or you have any issue following the guide, do let me know by leaving your thoughts in the comments section below. Rbc mobile app rbc banque directRBCMobile Banking apps let you bank, shop, pay and redeem RBC Rewards points from anywhere using your smartphone or tablet. COVID-19 – How RBC is helping clients. Read More The RBCMobileapp gives you personalized tools and insights so you can save, spend and manage your money with ease. Or text 'RBC' to 722722 and we'll send you the link Check Out Whats New! View your account details and transaction history for the last seven years. You can also set up and receive RBC Alerts about your banking activity and available RBC Offers. It’s a breeze to move money to your savings account, pay down your credit card, loan or credit line, or make a payment on your mortgage Easily access your RBC Royal Bank credit cards and credit lines. View your balance and available credit, make payments, apply for a new credit line or request a limit increase. Stay on top of your mortgage and loan details including your outstanding balance, interest rate and payment details. You can also skip a payment or make a double-up or lump sum payments on your mortgage. Track your RBC Royal Bank investments, RBC Direct Investing and RBC Dominion Securities accounts in one convenient place. Plus, contribute to your RRSP, renew GICs, buy RBC Mutual Funds and get personalized investment advice with My Advisor. Purchase foreign cash 24/7 through RBC Online Banking and pick it up at any of the 1,200 RBC branches in Canada. Have a question about your accounts or a recent transaction? Send us a message through our Secure Message Centre and we’ll get back to you within 48 hours. It’s a secure and convenient way to reach a helpful RBC representative. Purchase insurance coverage for your RBC loans, mortgages or credit cards or get travel insurance coverage for your next trip. When you bank online - or even with your mobile phone - you can easily check your balances, view your transactions or statements, pay bills and transfer funds at any time – wherever and whenever it’s convenient for you. And when you use RBC Online Banking, you also have access to my Finance Tracker – an online money management tool that automatically categorizes your expenses, letting you track your spending, set savings targets and create a budget in minutes. Online Banking is also an extremely safe and secure way to bank, so you can be confident your money is protected at all times. As a personal banking client you'll need your RBC Royal Bank Client Card or credit card to enrol. If you are an automotive finance, mortgage, credit line, Homeline, loan or investment client, you’ll need your account number and transit number. If you’d like to enrol your business account for Online Banking, you’ll need your RBC Royal Bank Business Client Card. Before you can make bill payments in Online Banking, you'll need to set up a list of payees. Sign in to Online Banking and select the 'Manage Payees' option from the Accounts Summary page. You can then choose “Add Payee” in the left side menu and follow the instructions. To make a payment online: Whether you're at home or away you can arrange to have payments and transfers made at a predetermined frequency or specified dates. Simply specify the amount and how often you want the transfers to occur (such as once a week, every 2 weeks or once a month). RBC Direct Investing Inc.*, RBC Dominion Securities Inc.* and Royal Bank of Canada are separate corporate entities which are affiliated. does not provide investment advice or recommendations regarding the purchase or sale of any securities. Investors are responsible for their own investment decisions. RBC Direct Investing is a business name used by RBC Direct Investing Inc. For a definition of an unauthorized transaction and for full details regarding the protections and limitations of the RBC Digital Banking Security Guarantee, please see your Electronic Access Agreement for personal banking clients, and the Client Card Agreement and the Master Client Agreement for business clients. This guarantee is given by Royal Bank of Canada in connection with its Online and Mobile Banking services. Cardholders are not liable for losses resulting from circumstances beyond their control provided they have taken reasonable precautions to protect their Client Card and PIN (if applicable) as set out in the Client Card Agreement. Formerly known as the RBC Online Banking Security Guarantee. Please note that each payment to a third party from your RBC Royal Bank credit card account is treated as a cash advance (up to your available credit and daily limits) and is subject to the standard annual interest rate applicable to your credit card account, from the day the cash advance is posted until the balance is paid in full. A $3.50 cash advance fee/transaction applies and will be charged to your credit card account. Maximum transaction limits may apply and are subject to change. If paying from a Royal Credit Line regular interest charges apply. Availability of the money will depend on the time when it is sent from RBC Royal Bank or RBC Bank. S.) account transaction history until the following day but will reflect the date of transfer. The products, services and securities referred to on this web site are only available in Canada and other jurisdictions where they may be legally offered for sale. The information on this web site should not be construed as an offer by RBC Dominion Securities to sell specific securities in any jurisdiction outside of Canada. An excess debit transaction fee may also apply depending on the deposit account used for purchase. If you purchase foreign cash using your credit card the transaction is treated as a Cash Advance. This means that Cash Advance fees apply and interest is charged from the date of your foreign cash purchase. The foreign exchange rate is final at the time you make the purchase. Depending on the branch you have chosen for pick-up, you can expect it to take anywhere from 3-10 business days to arrive at the bank. In most cases you can expect the cash to arrive in 3 business days. Maximum transaction limits may apply and are subject to change. Availability of the money will depend on the time when it is sent from RBC Royal Bank or RBC Bank. S.) account transaction history until the following day but will reflect the date of transfer. The Credit View Dashboard information is provided by Trans Union for educational purposes and is not intended to provide you with financial advice. We do not review or use Credit View Dashboard information, and Credit View Dashboard information cannot be interpreted as credit approval. As such, Royal Bank of Canada is not liable for any decision you make based on Credit View Dashboard information. For help with your financial needs and financial advice, please talk to us. In order for you to access the Credit View Dashboard, we must share your name, address and date of birth with Trans Union each time you click on the 'View Your Credit Score' link in Online Banking. By selecting Install, you consent to the installation of RBC® Canada¹, which is designed to make your banking experience more comfortable by taking advantage of the unique interactive features of Windows‡ 8. You are entitled to and consent to future updates or upgrades to RBC Canada, which may be automatically installed as per your device or operating system default or user-initiated settings. You may withdraw your consent by deleting RBC Canada from your device. FEATURES: VIEW ACCOUNT DETAILS View account details, and transaction history in an interactive graph for each of your personal and business accounts. TRANSFER FUNDS Transfer funds between existing CAD or USD RBC Royal Bank® accounts. VIEW & DELETE UPCOMING PAYMENTS View postdated payments or transfers scheduled in the next 30 days in a calendar format, with the ability to delete any of them in real time. PAY BILLS Pay any of your registered bills in CAD or USD. INTERAC‡ e-Transfers Send Interac e-Transfers to registered payees. BRANCH & ATM LOCATOR Locate the closest RBC Royal Bank Branch or ATM. Additional features Include both full and snap view, the masking of and support for multiple usernames/client card numbers and Live Tiles for Facebook‡, Twitter‡ and more. Additional Terms: SECURITY: We understand how important information security and privacy are to you. That’s why you’re protected no matter how you bank. If an unauthorized transaction is conducted through your RBC Royal Bank accounts through RBC Canada, you are covered by the RBC Online Banking Security Guarantee and will be reimbursed 100% for any resulting losses to those accounts. For assistance with removal of RBC Canada, access instructions at PRIVACY: You consent and acknowledge that RBC Canada performs functions to access services like finding a nearby RBC Royal Bank® branch or ATM. q=88 or contact [email protected] RBC Royal Bank contact information is available at: https:// ACCESS: To access banking through RBC Canada, simply use your existing RBC Royal Bank online banking client card or username and password. You will then be prompted to answer one of the Personal Verification Questions you set up for online banking. If you are not yet enrolled for online banking, call us 24 hours a day, seven days a week at 1-800-769-2555 and follow the prompts (TTY: 1-800 661-1275). RBC Canada is available in Canada only LEGAL: If you install RBC Canada, then you must review, and are subject to, the terms and conditions found under the Legal link on com, and the Electronic Access Agreement if you are a personal client of Royal Bank of Canada with RBC Royal Bank Online Banking. RBC and Royal Bank are registered trademarks of Royal Bank of Canada. 2 For a definition of an unauthorized transaction and full details regarding the protections and limitations of the RBC Online Banking Security Guarantee, please see your account and/or online agreements. This guarantee is given by Royal Bank of Canada in connection with its Online Banking service. ‡ All other trademarks are the property of their respective owner(s).
Rbc Online Banking App For Mac
With this update, add your RBC debit or credit card to Apple Pay straight from the app. Impossible d’accéder à mon compte bancaire pour faire des virements interac. Also, you’ll be able to manage your bills more easily from the new Pay Bills page. See your payees, schedule payments, view past payments and more, all in one place. L’application ne fonctionne plus depuis maintenant 8 jours. I am tempted to switch banks over this app becoming more and more garbage. En 2019 une application bancaire qui ne fonctionne pas pendant 8 jours c’est INACCEPTABLE!! Who ever is in charge of making this app less and less user friendly with every update should be fired. Bring back sign in with Touch ID without having to select it every time. RBC Online Banking is provided by Royal Bank of Canada. RBCMobile is operated by Royal Bank of Canada, RBC Direct Investing Inc. RBC Canada, RBC Wallet, RBC Rewards and RBC e Gift are operated by Royal Bank of Canada. For a definition of an unauthorized transaction and for full details regarding the protections and limitations of the RBC Digital Banking Security Guarantee, please see your Electronic Access Agreement for personal banking clients, and the Client Card Agreement and the Master Client Agreement for business clients. This guarantee is given by Royal Bank of Canada in connection with its Online and Mobile Banking services. Cardholders are not liable for losses resulting from circumstances beyond their control provided they have taken reasonable precautions to protect their Client Card and PIN (if applicable) as set out in the Client Card Agreement. Rbc mobile app rbc beddington For a definition of an unauthorized transaction and for full details regarding the protections and limitations of the RBC Digital Banking Security Guarantee, please see your Electronic Access Agreement for personal banking clients, and the Client Card Agreement and the Master Client Agreement for business clients. The RBCMobileapp takes mobile banking to the next level. Everyday banking is always convenient, but our new app helps make managing your money even easier. Our fresh and intuitive design gives you easy access to everything you’d expect from a banking app account balances, money transfers, bill payments, cheque deposits, ATM locations and more. RBCMobile Banking apps let you bank, shop, pay and redeem RBC Rewards points from anywhere using your smartphone or tablet. COVID-19 – How RBC is helping clients. Read More The RBCMobile* app takes mobile banking to the next level. Everyday banking is always convenient, but our new app helps make managing your money even easier. Our fresh and intuitive design gives you easy access to everything you’d expect from a banking app: account balances, money transfers, bill payments, cheque deposits, ATM locations and more. We made it easier to find each feature with improved navigation. The RBCMobile* app takes mobile banking to the next level. Our Action Button and Manage Menu take the most important tools and put them right at your fingertips. Everyday banking is always convenient, but our new app helps make managing your money even easier. Our fresh and intuitive design gives you easy access to everything you’d expect from a banking app: account balances, money transfers, bill payments, cheque deposits, ATM locations and more. We made it easier to find each feature with improved navigation. Exclusive to the RBCMobileapp, NOMI plays a big part of the app experience. Our Action Button and Manage Menu take the most important tools and put them right at your fingertips. NOMI Insights help you manage your day-to-day finances with personalized tips and spend trends. NOMI Find & Save helps make saving easy by taking a look at your spending habits to find a little extra money and saves it for you – so you don’t have to. We know you’ll love everything the RBCMobileapp offers, and we want you to feel safe and secure using it. Starting at sign in, we’ve given you access to the latest in biometric identification technology, like Touch ID or Face ID, so you can securely access the app without having to remember your password. If you misplace your credit card, use the app to temporarily lock your card. ------PRIVACYRBC collects, uses and discloses the information that you provide to us in accordance with your account agreement(s) with us and our privacy policy, available at Learn more about RBC digital channel privacy at RBCMobileapp might need to access device services for certain features, like finding nearby RBC Royal Bank® branches. For a full list of the features, check out For help removing the RBCMobileapp from your device, there are instructions at or you can contact [email protected]LEGALWhen you select to install the RBCMobileapp, you’re consenting to any future updates or upgrades. Depending on your device, operating system or user-initiated settings, these might be automatically installed. You’re able to withdraw your consent by uninstalling the RBCMobileapp from your device. If you download the RBCMobileapp, you must review, and are subject to, the terms & conditions found under the Legal link on com as well as all applicable agreements between you and any RBC company, including:- Electronic Access Agreement (Personal clients of Royal Bank of Canada)- Business Account Agreement (Business clients of Royal Bank of Canada)- The Operation of Account Agreement (RBC Direct Investing clients)- General Account Agreement (RBC Dominion Securities clients)*The RBCMobileapp is operated by Royal Bank of Canada, RBC Direct Investing Inc. Contact information for these entities is available at https:// Trademarks of Royal Bank of Canada. RBC and Royal Bank are registered trademarks of Royal Bank of Canada. App Advice does not own this application and only provides images and links contained in the i Tunes Search API, to help our users find the best apps to download. Touch ID, Face ID, Siri and i Message are trademarks of Apple Inc., registered in the U.